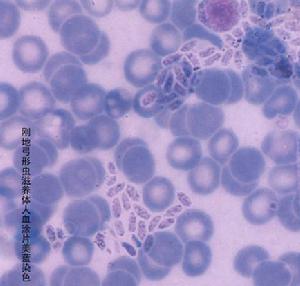
先天性風疹綜合徵

發病機理
 漿細胞
漿細胞先天感染風疹後可以發生流產、死產、有畸形的活產或完全正常的新生兒,也可為隱性感染胎兒幾乎所有的器官都可能發生暫時的、進行性或永久的病變。
臨床表現
 動脈導管未閉
動脈導管未閉2心臟的畸形 心血管方面的畸形最常見者為動脈導管未閉,有人甚至在導管的管壁組織中分離出風疹病毒。肺動脈狹窄或其分支的狹窄亦較多見其他尚可有房間隔缺損、室間隔缺損、主動脈弓異常以及更為複雜的畸形大多數患嬰出生時心血管方面的症狀並不嚴重;但亦有於生後第1個月內即有心力衰竭者,其預後不良。
3耳聾 失聽可輕可重,一側或兩側。其病變存在於內耳的柯替(Corti)耳蝸但亦有中耳發生病變者。失聽亦可分為先天風疹的唯一表現,尤多見於懷孕8周以後感染者。
4眼部缺陷 最為特徵性的眼部病變是梨狀核性的白內障,大多數為雙側,亦可單側常伴有小眼球。出生時白內障可能很小或看不到,必須以檢眼鏡仔細窺查除白內障外,先天性風疹亦可產生青光眼,與遺傳性的嬰兒青光眼很難鑑別先天性風疹的青光眼表現為角膜增大和混濁,前房增深,眼壓增高正常的新生兒亦可有一過性的角膜混
 白內障
白內障5發育障礙及神經方面的畸形 胎內感染風疹對中樞神經亦能致病。患嬰屍檢時證實風疹病毒對神經組織毒力很強,造成程度不同的發育缺陷腦脊液中常有改變如細胞數增多、蛋白質濃度增高,甚至1歲時仍可從腦脊液分離出病毒。
智力行為和運動方面的發育障礙亦為先天性風疹的一大特點。此種早期發育障礙系由於風疹腦炎所致,可能造成永久性的智力遲鈍。
一般說來先天性心臟畸形、白內障及青光眼往往由於孕期最初2~3月內的病毒感染,而失聽及中樞神經的病變往往由於孕期較晚受感染新生兒亦可用一過性的先天性風疹表現,往往為妊娠早期感染所傳遞,偶爾由於妊娠晚期感染母親與胎兒同時發病。
診斷
 血液標本
血液標本1.流行病學資料 孕婦於妊娠初期有風疹接觸史或發病史。並在實驗室已得到證實母體已受風疹感染。
2.出生後小兒有一種或幾種先天缺陷的表現。
3.嬰兒早期在血清或腦脊液標本中存在特異性風疹IgM抗體。
4.小兒在出生後8~12個月被動獲得母體抗體已不存在時,連續血清標本中仍持續出現相當水平的風疹抗體。
鑑別診斷
弓形蟲
弓形蟲風疹患者的皮疹形態介於麻疹與猩紅熱之間,因此應著重對此種常見的發熱出疹性疾病進行鑑別診斷。
此外,風疹尚需與幼兒急疹藥物疹傳染性單核細胞增多症、腸道病毒感染如柯薩奇病毒A組中型及B組中型、埃可病毒型感染相鑑別。
先天性風疹綜合徵還需與宮內感染的弓形蟲病、巨細胞病毒感染、單純皰疹病毒感染相鑑別。此種胎內感染與先天性風疹有相類似的症狀。
併發症
 特發性血小板減少性紫癜
特發性血小板減少性紫癜較重者有下述幾種:
(1)腦炎 少見,主要見於小兒般發生於出疹後1~7天。有頭痛、嗜睡、嘔吐、復視、頸部強直、昏迷、驚厥、共濟失調、肢體癱瘓等腦脊液的改變。與其他病毒性腦炎相似,病程比較短,多數患者於3~7天后自愈,少數可留後遺症也可有慢性進行性全腦炎。
 毛細血管通透性增強
毛細血管通透性增強(3)關節炎 主要見於成年人,特別是婦女患者。我國已有兒童風疹性關節炎的報導,發生原理尚未完全明確,多系病毒直接侵襲關節腔或免疫反應所致出疹期間指關節、腕關節、膝關節等紅腫痛,關節腔積液內含單核細胞,有時數個關節相繼腫痛,類似風濕性多發性關節炎,但多在數天內自行消失。
(4)出血傾向 少見。由於血小板減少和毛細血管通透性增高所致。常在出疹後突然出血出現皮膚黏膜瘀點、瘀斑、嘔血、便血、血尿多在數周內自行緩解。少數病人顱內出血可引起死亡。
其他可有肝腎功能異常。
輔助檢查
 風疹病毒
風疹病毒2.血清學檢查 當孕婦有風疹接觸史或臨床上有疑似風疹的症狀時,應測定血清風疹抗體。如果特異性抗風疹IgM陽性(ELA測定IgM試劑盒),說明近期曾有過風疹的初次感
 風疹疫苗
風疹疫苗治療
對先天性風疹綜合徵的治療僅為對症療法,並由具有風疹抗體的人擔任護理職務,出院以後還須禁忌與孕婦接觸。
預防
 丙種免疫球蛋白
丙種免疫球蛋白